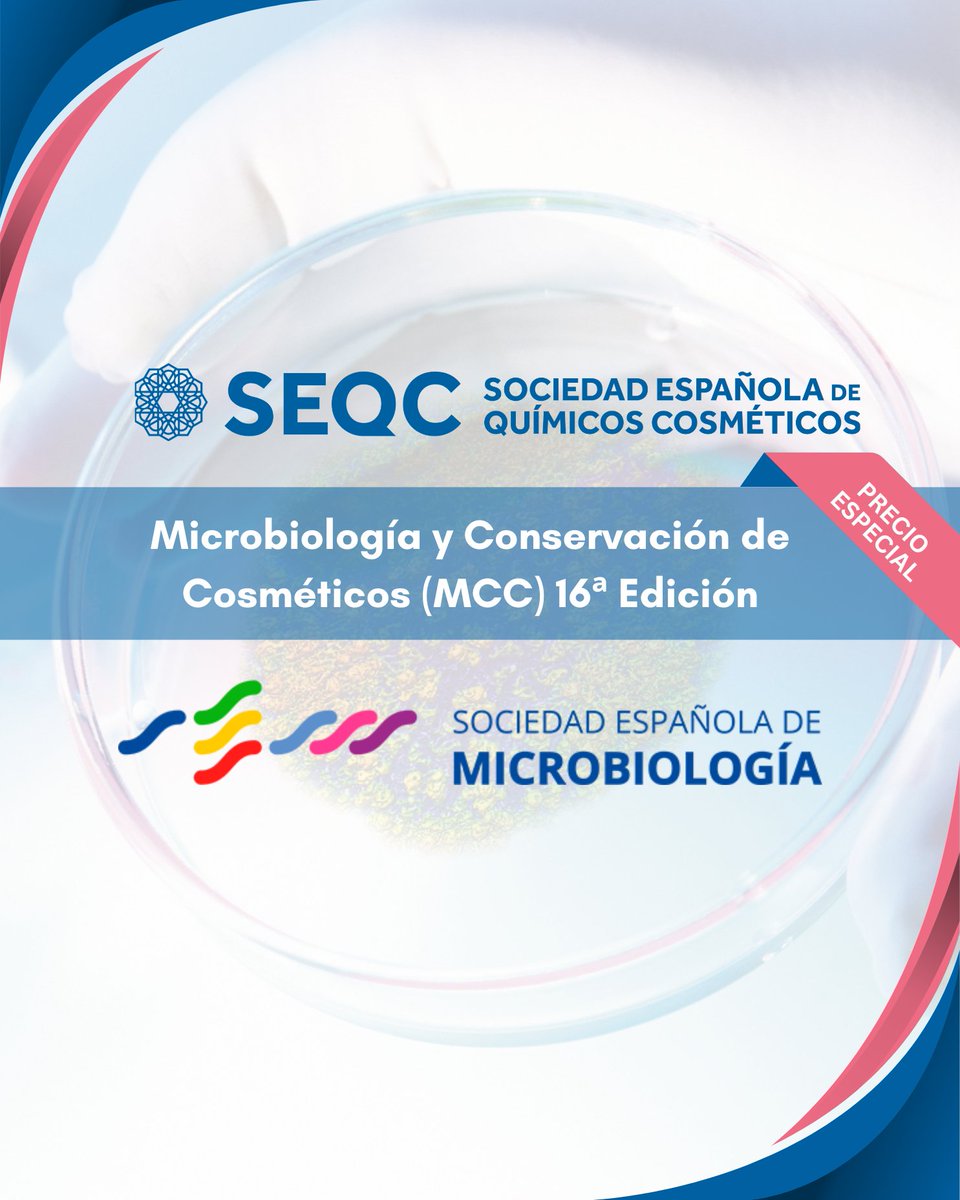
SEQC tweet media

🍸 #somosSEQC
¿Eres estudiante o recién graduado/a y socio SEQC? Esto es para ti 👇
Vuelve el cóctel networking para jóvenes del sector cosmético.
📅 Barcelona — 4 junio
📅 Madrid — 12 junio
⚠️ Inscripciones: 6 mayo
Plazas limitadas
#Networking #Cosmética #JóvenesProfesionales

Español